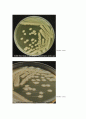
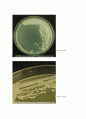
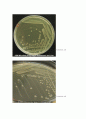

본문내용
기위한 방법은 콜로니 선택의 가장 중요한 요소이다.
(3) 먹이의 분포콜로니를 선택하는 경우는 반드시 주변에 먹이가 편재해 있어야한다.상당히 넓은 반경내에서 먹이를 구할 수 가 없다면 콜로니는 형성되지 않거나, 형성했다 해도 다른 곳으로 이동을 한다.
(4) 위험요소일본왕의 경우는 물을 매우 싫어한다. 만약 주변 가까이에 물이 흐르고 있다면 콜로니를 선택하지 않을 것이다.또한 어떤종은 매우 습한지역을 좋아하는종도 있다.사람의 경우 지하에 수맥이 있을 경우에는 인체에 큰 영향을 미친다고 알려져있다. 운영자도 그동안 생물을 취급하면서 수맥위에서는 생물이 제대로 성장할 수 없다는 것을 경험한바 있다. 모든 곤충들은 이러한 위험을 피할 수 있는 본능적인 기능들이 있을것으로 추정하고 있다.
(5) 월동개미는 일정온도 이상의 온도가 유지되지 않는 곳에서는 월동할 수가 없다. 자연상태에서 월동할 수 있는 장소는 땅속, 그리고 비교적 둥치가 큰 나무속이다. 따라서 이러한 월동에 대한 대안이 없이 콜로니를 형성하지 않는다.그 외 장소를 선택하는 기준은 여러 가지가 있을 것이다.
나. 콜로니의 이동
한번 건설된 콜로니가 영원히 같은 장소에 지속되는 것은 아니며 외부 환경여건이 좋지 못하게 변하면 다른곳으로 이동한다. 이러한 변화의 요인은 주로 자연환경에 의한 것인데 위에서 검토한바있는 선택기준들이 변하기 때문이다. 가령 예를 들면 비가 많이 왔을 경우 지형지물의 변화, 먹이 환경의 변화, 온습도의 변화 등이다. 그물등개미는 한 콜로니 내에 수만마리가 있는 것이 보통인데 긴 행령을 이룬체(a line of ants) 다른곳으로 이동하는 모습을 자주 볼 수 있다. 이런 경우는 대부분 콜로니에 물이 들었거나 심하게 파괴되었을 경우 등이다.
다. 임시 콜로니
대부분의 수상영소형의 콜로니는 임시적인 성격을 갖는다.임시 콜로니는 계절적요인으로 인해 임시적으로 운영되는 콜로니를 말하며 주로 번식기에 이러한 임시 콜로니가 형성이 된다. 이러한 콜로니는 주로 나무 위에서 먹이활동을 하는 종일 경우, 봄부터 가을까지 번식 기간이나 먹이활동을 하는 동안만 나무위에 콜로니를 운영하고 가을이되면 본콜로니를 나무 밑 땅속에 형성하고 겨울을 난다. 나무위나 수피 속에서는 쉽게 열을 얻을 수 있고 먹이 운반이 편리하기는 하나 겨울철 동면하기가 불가능하기때문으로 추정된다. 나무 홈 속에콜로니를 형성하고겨울을 나는 종도 많으나 이렇게 임시적으로 나무위에 서식하는 종이 많다. 이러한 경우는 진정한 수상 영소성이라 보기는 어렵다. 이들은 땅 속깊이에서 동면할 뿐 아니라 위험이 닥치면 땅속으로 들어간다.
2. 지중 영소
가. 지중영소의 특징
(1) 지중영소일 경우는 땅속에 여러래의 방을 만들어 사용한다.(2) 지상에 있는 지형지물을 이용하여 지표 가까이에서 열을 얻는다.돌이나 풀숲, 나무그루터기 등.(3) 땅속에 방이나 터널을 구축해야 함으로 흙을 외부로 반출한 흔적을 남긴다.즉 출입구가 반출된 흙이나 먹이의 퇴적물로 입구를 형성한다.(4) 겨울 동면시는 땅속 깊이 들어가 지하열을 이용한다.
나. 내부구조
▶수확개미는 말굽형으로서 수직으로 깊이 형성된다.
▶지표의 돌밑에 형성된 유충과 번데기가 있던방
다. 외부출입구와 퇴적물
외부 출입구는 왕국의 규모가 커지면 여러개의 출입구가 형성된다.반출된 흙이나 퇴적물의 량으로 군체의 크기를 추정할 수 있을까?어느정도 상관관계는 있으나 반드시 비례하는 것은 아니다.왜냐하면 지하에 이미 형성된 공간이 있었다면 반출량이 없이도 많은 수자의 개미가 서식할 수도 있기 때문이다.퇴적물로 종을 식별할 수가 있을까?어느 정도는 가능하나 정확하게 알아 맞추기는 어렵다.일본왕의 경우는 개체의 크기가 매우 크며 힘이쎄다. 따라서 반출된 흙이나 모래의 입자가 매우 굵다.그외 소형일수록 흙이나 모래의 입자가 작다는 것을 알수 있다. 즉 흙이나 모래의 입자를 보고 초소형, 소형, 중형, 대형의 구분은 가능하다.곰개미의 퇴적물은 다른 개미와 어떻게 다른가?일본왕이나 대부분의 지중영소형의 경우는 퇴적물이 모래나 흙이며 비교적 깨끗한 편이다. 그러나 곰개미의 경우는 마른 나무조각, 풀조각 등 잡다한 반출물이 많으며 특히 먹이 퇴적물이 많이 섞여있다. 일본왕은 먹이 습성이 호밀성에 가깝기 때문에 먹이 퇴적물이 많지 않으나 곰개미의 경우는 육식성에 가까우므로 곤충의 시체 중 먹고남은 쓰레기들이 반출되어 나오기 때문이다. 또한 장소를 선택하는데 있어 풀뿌리, 잡초 등이 서로 엉켜있는곳을 선호하기 때문으로 추정된다.
▶일본왕개미의 전형적인 출입구 모습
▶곰개미 콜로니의 퇴적물
라. 그루터기 영소
그루터기란 나무나 풀 따위를 베고 남은 믿동을 말한다.이러한 그루터기는 땅과 연결되어 있어 보습효과가 좋고 더구나 목질이 산화되어가는 과정에서 내부에서 많은 열이 발생됨으로 개미의 서식처로서는 안성맞춤이다. 따라서 이라한 그루터기의 껍질을 제처보면 많은 종류의 개미가 서식한다.나무를 벤지가 얼마되지 않은 생목일 경우에는 개미가 서식하지 못하며 몇 년에 걸처 비바람에 의해 썩어 있을 때 좋은 장소가 된다. 이러한 그루터기에 서식하는 종은 대부분 소형종이며 대형종은 발견되지 않는다.
▶유충과 고치를 목질과 껍질 사이에 보관한다.
3. 수상영소
생목에 발생된 큰 홈(수목의 폐공부)은 개미가 서식하기에 매우 좋은 환경을 제공한다. 적정한 수분이 유지될 뿐 아니라 홈의 깊이가 있어 동면하기에도 쉽기 때문이다. 마찬가지로 큰 고목일 경우에도 1년내내 개미가 서식할 수 있다. 그러나 땅위에 쓰러진 조그마한 나무일 경우는 임시 콜로니로 이용될 뿐이며 겨울에는 땅속으로 들어가 동면한다.
▶이 홈속에는 가시개미가 수천마리 서식하고 있으니 그야말로 철옹성이다. 지네나 뱀이 들어간다면 몇초를 견디지 못하고 도망처야 할 것이다.
▶나무위에서 활동하는 대부분의 개미는 콜로니가 뿌리부근의 땅속에 있는 경우가 많으며 나무위에서 활동하는 이유는 진딧물의 단물이나 수액을 먹기 위해서이다. 수상영소란 번식과 동면을 나무위에서 하는 것을 말하며 일시적으로 증식기간동안만 나무위에 있는 경우와는 구분해야 할 것이다.
(3) 먹이의 분포콜로니를 선택하는 경우는 반드시 주변에 먹이가 편재해 있어야한다.상당히 넓은 반경내에서 먹이를 구할 수 가 없다면 콜로니는 형성되지 않거나, 형성했다 해도 다른 곳으로 이동을 한다.
(4) 위험요소일본왕의 경우는 물을 매우 싫어한다. 만약 주변 가까이에 물이 흐르고 있다면 콜로니를 선택하지 않을 것이다.또한 어떤종은 매우 습한지역을 좋아하는종도 있다.사람의 경우 지하에 수맥이 있을 경우에는 인체에 큰 영향을 미친다고 알려져있다. 운영자도 그동안 생물을 취급하면서 수맥위에서는 생물이 제대로 성장할 수 없다는 것을 경험한바 있다. 모든 곤충들은 이러한 위험을 피할 수 있는 본능적인 기능들이 있을것으로 추정하고 있다.
(5) 월동개미는 일정온도 이상의 온도가 유지되지 않는 곳에서는 월동할 수가 없다. 자연상태에서 월동할 수 있는 장소는 땅속, 그리고 비교적 둥치가 큰 나무속이다. 따라서 이러한 월동에 대한 대안이 없이 콜로니를 형성하지 않는다.그 외 장소를 선택하는 기준은 여러 가지가 있을 것이다.
나. 콜로니의 이동
한번 건설된 콜로니가 영원히 같은 장소에 지속되는 것은 아니며 외부 환경여건이 좋지 못하게 변하면 다른곳으로 이동한다. 이러한 변화의 요인은 주로 자연환경에 의한 것인데 위에서 검토한바있는 선택기준들이 변하기 때문이다. 가령 예를 들면 비가 많이 왔을 경우 지형지물의 변화, 먹이 환경의 변화, 온습도의 변화 등이다. 그물등개미는 한 콜로니 내에 수만마리가 있는 것이 보통인데 긴 행령을 이룬체(a line of ants) 다른곳으로 이동하는 모습을 자주 볼 수 있다. 이런 경우는 대부분 콜로니에 물이 들었거나 심하게 파괴되었을 경우 등이다.
다. 임시 콜로니
대부분의 수상영소형의 콜로니는 임시적인 성격을 갖는다.임시 콜로니는 계절적요인으로 인해 임시적으로 운영되는 콜로니를 말하며 주로 번식기에 이러한 임시 콜로니가 형성이 된다. 이러한 콜로니는 주로 나무 위에서 먹이활동을 하는 종일 경우, 봄부터 가을까지 번식 기간이나 먹이활동을 하는 동안만 나무위에 콜로니를 운영하고 가을이되면 본콜로니를 나무 밑 땅속에 형성하고 겨울을 난다. 나무위나 수피 속에서는 쉽게 열을 얻을 수 있고 먹이 운반이 편리하기는 하나 겨울철 동면하기가 불가능하기때문으로 추정된다. 나무 홈 속에콜로니를 형성하고겨울을 나는 종도 많으나 이렇게 임시적으로 나무위에 서식하는 종이 많다. 이러한 경우는 진정한 수상 영소성이라 보기는 어렵다. 이들은 땅 속깊이에서 동면할 뿐 아니라 위험이 닥치면 땅속으로 들어간다.
2. 지중 영소
가. 지중영소의 특징
(1) 지중영소일 경우는 땅속에 여러래의 방을 만들어 사용한다.(2) 지상에 있는 지형지물을 이용하여 지표 가까이에서 열을 얻는다.돌이나 풀숲, 나무그루터기 등.(3) 땅속에 방이나 터널을 구축해야 함으로 흙을 외부로 반출한 흔적을 남긴다.즉 출입구가 반출된 흙이나 먹이의 퇴적물로 입구를 형성한다.(4) 겨울 동면시는 땅속 깊이 들어가 지하열을 이용한다.
나. 내부구조
▶수확개미는 말굽형으로서 수직으로 깊이 형성된다.
▶지표의 돌밑에 형성된 유충과 번데기가 있던방
다. 외부출입구와 퇴적물
외부 출입구는 왕국의 규모가 커지면 여러개의 출입구가 형성된다.반출된 흙이나 퇴적물의 량으로 군체의 크기를 추정할 수 있을까?어느정도 상관관계는 있으나 반드시 비례하는 것은 아니다.왜냐하면 지하에 이미 형성된 공간이 있었다면 반출량이 없이도 많은 수자의 개미가 서식할 수도 있기 때문이다.퇴적물로 종을 식별할 수가 있을까?어느 정도는 가능하나 정확하게 알아 맞추기는 어렵다.일본왕의 경우는 개체의 크기가 매우 크며 힘이쎄다. 따라서 반출된 흙이나 모래의 입자가 매우 굵다.그외 소형일수록 흙이나 모래의 입자가 작다는 것을 알수 있다. 즉 흙이나 모래의 입자를 보고 초소형, 소형, 중형, 대형의 구분은 가능하다.곰개미의 퇴적물은 다른 개미와 어떻게 다른가?일본왕이나 대부분의 지중영소형의 경우는 퇴적물이 모래나 흙이며 비교적 깨끗한 편이다. 그러나 곰개미의 경우는 마른 나무조각, 풀조각 등 잡다한 반출물이 많으며 특히 먹이 퇴적물이 많이 섞여있다. 일본왕은 먹이 습성이 호밀성에 가깝기 때문에 먹이 퇴적물이 많지 않으나 곰개미의 경우는 육식성에 가까우므로 곤충의 시체 중 먹고남은 쓰레기들이 반출되어 나오기 때문이다. 또한 장소를 선택하는데 있어 풀뿌리, 잡초 등이 서로 엉켜있는곳을 선호하기 때문으로 추정된다.
▶일본왕개미의 전형적인 출입구 모습
▶곰개미 콜로니의 퇴적물
라. 그루터기 영소
그루터기란 나무나 풀 따위를 베고 남은 믿동을 말한다.이러한 그루터기는 땅과 연결되어 있어 보습효과가 좋고 더구나 목질이 산화되어가는 과정에서 내부에서 많은 열이 발생됨으로 개미의 서식처로서는 안성맞춤이다. 따라서 이라한 그루터기의 껍질을 제처보면 많은 종류의 개미가 서식한다.나무를 벤지가 얼마되지 않은 생목일 경우에는 개미가 서식하지 못하며 몇 년에 걸처 비바람에 의해 썩어 있을 때 좋은 장소가 된다. 이러한 그루터기에 서식하는 종은 대부분 소형종이며 대형종은 발견되지 않는다.
▶유충과 고치를 목질과 껍질 사이에 보관한다.
3. 수상영소
생목에 발생된 큰 홈(수목의 폐공부)은 개미가 서식하기에 매우 좋은 환경을 제공한다. 적정한 수분이 유지될 뿐 아니라 홈의 깊이가 있어 동면하기에도 쉽기 때문이다. 마찬가지로 큰 고목일 경우에도 1년내내 개미가 서식할 수 있다. 그러나 땅위에 쓰러진 조그마한 나무일 경우는 임시 콜로니로 이용될 뿐이며 겨울에는 땅속으로 들어가 동면한다.
▶이 홈속에는 가시개미가 수천마리 서식하고 있으니 그야말로 철옹성이다. 지네나 뱀이 들어간다면 몇초를 견디지 못하고 도망처야 할 것이다.
▶나무위에서 활동하는 대부분의 개미는 콜로니가 뿌리부근의 땅속에 있는 경우가 많으며 나무위에서 활동하는 이유는 진딧물의 단물이나 수액을 먹기 위해서이다. 수상영소란 번식과 동면을 나무위에서 하는 것을 말하며 일시적으로 증식기간동안만 나무위에 있는 경우와는 구분해야 할 것이다.

소개글